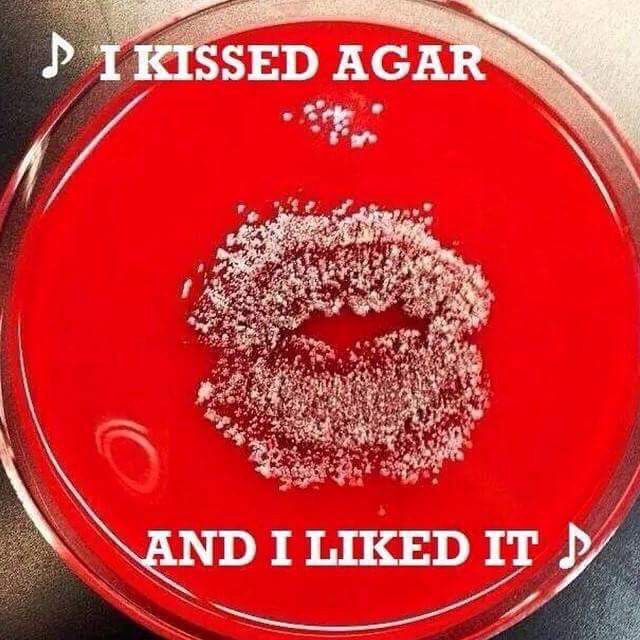
25ddd1d1c1ac095316ee48661692cc97

Back forty-odd years ago when I was still in high school, my classmates and I grew bacteria as one of our various experiments in BIO 11. It was a particularly disgusting (and incredibly fun!) experiment because our frequently drunk Biology teacher (who’d been fired from the boys’ school down the road, but was apparently eminently hirable for our all-girls school) gave us free rein: after we’d set up our plates with blood agar, he set us free in the school, each of us clutching a handful of Q-tips in pursuit of our germs.
My choice was rather mundane: the mouthpiece of the pay phone the boarders used to call their boyfriends. My friend chose the toilet seat in the first stall of the busiest bathroom. The most most interesting choice was by a young woman who merely kissed the blood agar .
Every day or two, we’d check our plates for growth, and the results were surprising: while the pay phone source proved to be a rich source of bacteria, the toilet-seat bacteria barely grew. The biggest surprise, however, was the kiss, which produced a lush garden of bacteria in the shape of puckered lips!
Because of that experiment, I always assumed that all agar was made from animal products, which is not, in fact the case. Indeed, while blood agar, an effective bacterial growth medium, is derived from the blood of sheep, “agar agar” (no, that’s not a typo!) is derived from algae.
As I’ve begun to delve deeper into vegan cooking, I’ve started to notice that a number of vegan recipes–particularly those that attempt to recreate dairy products–contain agar, so last week, I ordered up a couple of packages from my good friends at Amazon. It’s a fine, white powder sold in 2-ounce packages, and for the exorbitant price, you’d swear it was cocaine.
Now, I’ve been on the lookout for a vegan mayonnaise that doesn’t include huge amounts of extracted oil (as opposed to oil in the ingredients, like cashews) or a block of tofu, which I always find a bit off-putting. Today, I came across a recipe that looked perfect and also gave me the opportunity to experiment with my new product.
I won’t reproduce the recipe because I’ve made no adjustments. The recipe was created by Bryanna Clark Grogan and is rather amazing: Low-Fat Vegan Mayo.
I cannot believe I’ve never come across Bryanna Clark Grogan’s blog until this point because everything she posts looks like the bomb-diggity–I’ll be creeping on that blog for days! And, as it turns out, Ms. Clark Grogan has also written several vegan cookbooks (so my good friends at Amazon may be getting a few orders in the coming days).
The WEIRDEST part of it all: as I was perusing her various recipes, I realized she lives on the SAME island we do: how random is THAT?
Back to the recipe: all it requires is the following ingredients, and the only obscure one is the agar:

You basically blend the almond milk, cashews, vinegar, mustard, and salt, and then cook the agar and corn starch in water until it turns into a translucent goo the colour and texture of liquid cement (remember that stuff?):

And it thickens up surprisingly quickly!

You just add the gooey mixture to the other ingredients in the blender and blend like hell until it’s all emulsified. It’s not super thick at first, but firms up in the fridge to the point where you can stand a knife up in it! The recipe makes two cups, but I used a gigantic jar because…that’s what I had.

And, as it turns out, my friend who kissed her agar plate was not all that original. Indeed, I found this meme online!
And, of COURSE, the song of the day is Katy Perry’s “I Kissed a Girl, I Liked It.”
One thought on “Agar Agar…and an Excellent (and Easy!) Low-Fat Vegan Mayo!”